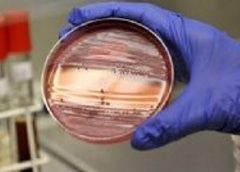

На чемпіонаті світу з водних видів спорту збірна України з синхронного плавання, яка складається з харків’янок, здобула золото.
Читати даліЛипень 2019
На Харківщині можливий спалах кишкових інфекцій у дітей – ОЛЦ
Масові порушення санітарних вимог у дитячих навчальних закладах регіону виявили фахівці обласного лабораторного центру.
Читати даліСуд залишив без змін запобіжні заходи двом підозрюваним у фейкових повідомленнях про замінування
Обидва підозрюваних вже вийшли з-під варти під заставу.
Читати даліУ Харкові на перехресті знайшли тіло чоловіка
Видимих ознак насильницької смерті на тілі мертвого не виявлено.
Читати даліВелогонщик з Харківщини здобув «срібло» чемпіонату Європи
Попереду у спортсмена чемпіонат світу з велоспорту ВМХ, який відбудеться наприкінці липня в Бельгії.
Читати даліКБ ім. Морозова сплатило 56,7 млн гривень за “воздух” – слідство
Протягом двох років підприємство сплачувало приватній фірмі гроші за колісні редуктори, що так і не були поставлені.
Читати даліЕксперти назвали річку на Харківщині, у якій не можна купатися
Відпочивальникам у місті Краснокутськ Харківської області не радять купатися на місцевому пляжі.
Читати даліУ п’яти вишах Харкова вибухівки не знайшли
Фахівці обстежили 6200 кв. метрів приміщень та понад 1 тисячу кв. метрів прилеглої території об’єктів, евакуювали 900 громадян.
Читати даліДиректору КП загрожує до п’яти років в’язниці через мільйонні збитки підприємства
Через занижені у вісім разів цін комунальне підприємство недоотримало понад 2,7 мільйонів гривень.
Читати даліАгітація на концерті та роздача харчів – на Харківщині виявили нові порушення виборчого законодавства
Всього з початку передвиборчої кампанії поліцією Харківщини зареєстровано 319 повідомлень про порушення Закону України «Про вибори народних депутатів України».
Читати далі